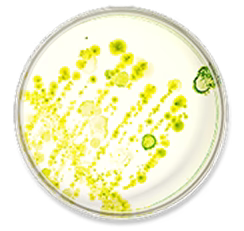

Proba Gluco Metabolism Balance
Proba Gluco Metabolism Balance
- Medicijn- en hormoonvrij alternatief voor Ozempic® en andere injecties op basis van semaglutide
- Bevordert het natuurlijke verzadigingsgevoel tot wel 65%
- Vermindeert de eetlust en geeft sneller een vol gevoel
- Vermindert de opname van suikers en koolhydraten tot 40%
- Verlaagt de bloedsuikerspiegel en ondersteunt een gezond metabolisme
- 60 capsules per verpakking
- Wetenschappelijk onderbouwde formuleMet Lactobacillus paracasei D3-5, Reducose®, berberine, chroom en cichorei
- Snel werkendKlinisch bewezen werking binnen enkele minuten
Koop meer, bespaar meer!




Kan beschikbaarheid voor afhalen niet laden
-
Gratis verzending vanaf € 30
-
Levertijd 1-2 werkdagen
-
90 dagen geld-terug-garantie












Proba Gluco Metabolism Balance
-
Hormoonvrij
-
Glutenvrij
-
Fructosevrij
-
Niet-GGO
-
Veganistisch
-
Zonder suiker
Inklapbare content
Ingrediënten
Indiase berberis wortel-extract (Berberis aristata DC.), witte moerbeiblad-extract (Morus alba L.), capsulewand: hydroxypropylmethylcellulose, maïszetmeel, maïsvezel, bacteriestam: Lactobacillus paracasei D3-5 (hittegeïnactiveerd), cichoreiwortel-extract (Cichorium intybus L.), antiklontermiddel: magnesiumzouten van vetzuren, chroompicolinaat
Gebruik
Volwassenen nemen dagelijks 2 capsules met voldoende water in, zonder te kauwen.
Belangrijke opmerkingen
De aanbevolen dagelijkse dosering niet overschrijden. Voedingssupplementen zijn geen vervanging voor een gevarieerde, evenwichtige voeding en een gezonde levensstijl. Koel, droog en buiten bereik van jonge kinderen bewaren.
Waarom het verzadigingsgevoel belangrijk is

Het lichaam maakt na het eten signalen aan die de eetlust reguleren en bijdragen aan een gevoel van verzadiging. Deze processen spelen een essentiële rol in het behouden van een gezonde bloedsuikerspiegel en stofwisseling. Helaas kunnen leeftijd, voeding en leefstijl deze processen verstoren.
Proba Gluco Metabolism Balance helpt dit natuurlijke verzadigingsgevoel te activeren. Het ondersteunt zo de eetlustregulatie, bloedsuikerbalans en een gezond metabolisme. Met toegevoegde bacteriën en cichorei ondersteunt het ook een gezonde darmflora, vermindert het de doorlaatbaarheid van de darmwand en bevordert het de spijsvertering.
Wetenschappelijk onderbouwde werking – binnen enkele minuten
-
65%Toename van verzadigingssignalen
-
-42%Daling van bloedsuikerspiegel
-
-41%Daling van insulinerespons
Hoe werkt het verzadigingsproces in je lichaam?
- 1Zodra je eet, starten er natuurlijke processen in je lichaam via de verbinding tussen je darmen en hersenen. Voedingsstoffen in het spijsverteringskanaal activeren signalen die bijdragen aan een gevoel van verzadiging.
- 2Deze signalen komen in de bloedbaan terecht en communiceren met verschillende organen, waaronder de alvleesklier.

- 3Ze stimuleren onder andere de insulineproductie, reguleren het eetgedrag en beïnvloeden de snelheid waarmee je maag zich leegt.
- 4Zo helpen deze processen je sneller vol te voelen en ondersteunen ze een gezonde stofwisseling. Leeftijd, leefstijl en dieet kunnen dit verzadigingssysteem echter verstoren – en precies daar zetten wij op in.
Onze zorgvuldig geselecteerde ingrediënten

Gegarandeerde hoge werkzaamheid
Voor maximale werkzaamheid maken we gebruik van speciale Activ-Vial™ verpakkingen. Deze potten bevatten een actieve voering die vocht absorbeert en zo de stabiliteit van de ingrediënten optimaal behoudt.
FAQ
-
Hoe werkt Proba Gluco Metabolism Balance?
Het supplement ondersteunt natuurlijke verzadigingssignalen, helpt de eetlust te verminderen en draagt bij aan een evenwichtige bloedsuikerspiegel en insulinerespons. Het bevat daarnaast ingrediënten die de darmgezondheid ondersteunen, zoals bacteriën, Reducose®, berberine en cichorei.
-
Hoe snel werkt het?
De werking is klinisch bewezen binnen enkele minuten na inname.
-
Hoe gebruik ik het?
Neem dagelijks 2 capsules met voldoende water. Niet kauwen. De aanbevolen dagelijkse dosering niet overschrijden.
-
Hoe lang kan ik het gebruiken?
Het supplement is bedoeld voor dagelijks gebruik en kan zo lang worden ingenomen als je er voordeel van ervaart.
-
Welke ingrediënten bevat het supplement?
- 12 bacteriestammen (5 miljard CFU) voor de darmgezondheid; - Reducose® (250 mg), helpt bij een evenwichtige koolhydraatstofwisseling; - Berberine (250 mg), ondersteunt de bloedsuikerbalans; - Chroom (6 mcg), ondersteunt de stofwisseling en bloedsuikerregulatie; - Cichorei (20 mg), ondersteunt de spijsvertering en levergezondheid
-
Is het geschikt bij dieetrestricties?
Ja, het is glutenvrij, fructosevrij, vegan, non-GMO en bevat geen toegevoegde suikers. Kan ik dit supplement combineren met andere medicatie? Raadpleeg altijd je arts voordat je met een nieuw supplement begint, vooral als je medicijnen gebruikt of een medische aandoening hebt.
-
Kan ik het gebruiken tijdens de zwangerschap?
Dit supplement bevat bacteriestammen die van nature in het menselijke microbioom voorkomen, ook bij zwangere vrouwen. Het product is echter niet specifiek onderzocht bij zwangere of borstvoedende vrouwen. Vraag je arts of verloskundige om advies.
-
Zijn er gezondheidsproblemen die invloed kunnen hebben op het effect?
Als je een medische aandoening hebt die het moeilijk maakt om op gewicht te blijven, overleg dan met je arts over wat het beste bij jou past.
-
Zijn er bijwerkingen?
Bij de start van een nieuw supplement kan er een gewenningsperiode zijn. Je kunt lichte spijsverteringsklachten ervaren zoals gasvorming, een opgeblazen gevoel, misselijkheid of dunne ontlasting. Deze verdwijnen meestal binnen 14 dagen. Als klachten aanhouden of ernstig zijn, raadpleeg dan je arts.
-
Vervangt dit supplement een gezonde voeding?
Nee. Het is een aanvulling en geen vervanging van een evenwichtige voeding of gezonde levensstijl.

Wij kunnen je helpen?
-
E-mail ons op info@nupure.eu
-
Bel ons +31 (0)232661720
Blijf op de hoogte
Exclusieve acties, productlanceringen en het laatste wetenschappelijk nieuws over darmflora in je mailbox.
- Een selectie kiezen resulteert in het geheel verversen van de pagina.
- Opent in een nieuw venster.